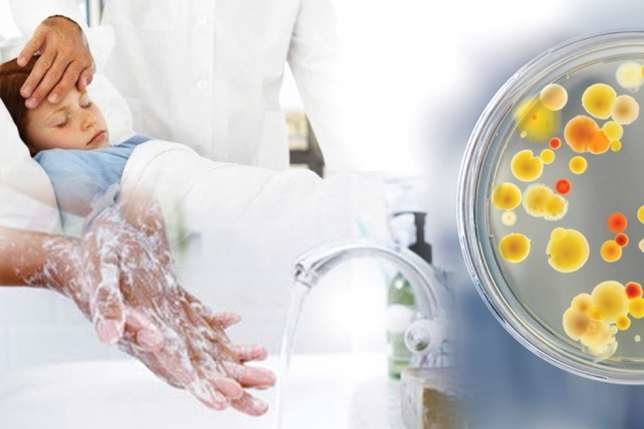

19 вересня в Тернополі зареєстровано п’ять випадків гастроентероколіту серед вихованців одного з дитячих садків обласного центру. Про це повідомило Головне управління Держпродспоживслужби в Тернопільській області.
З попереднім діагнозом гастроентероколіт до інфекційного відділення госпіталізовано четверо дітей. Одна дитина отримує лікування в амбулаторних умовах.
З метою встановлення причин та умов виникнення захворювань фахівцями Держпродспоживслужби розпочато санітарно-епідеміологічне розслідування спалаху та обстеження даного дошкільного навчального закладу з відбором проб для проведення відповідних лабораторних досліджень.
На даний момент відібрано взірці їжі, проби води, змиви з рук та спецодягу працівників. Розпорядженням начальника Головного управління Держпродспоживслужби в Тернопільській області Василя Хомінця з 23 вересня призупинено роботу у групі, де зареєстровано спалах.
Джерело: Тижневик "Номер один"



